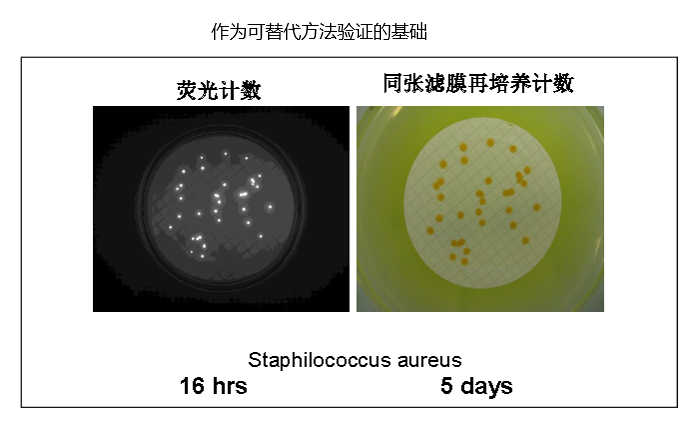
新闻图片3

支链淀粉酶 微生物
¥1422.35
推荐产品
公司新闻/正文
后疫情时代,更快更准确的微生物快检加速产品放行
1303 人阅读发布时间:2020-08-07 10:25
伴随新冠肺炎疫情发展,普通人从对疫情本身的关注越来越多地转移到对公共卫生和科学防疫工作的关注上,而由疫情引发的对病毒、微生物感染的关注需求急剧上升。
此时,更有效地监测产品质量,对生产过程的微生物污染监控对于企业而言非常重要。然而,传统的微生物学方法非常缓慢,需要数天才能得到结果。为了跟上现今产量增长的需求,您需要更快更准确地得到结果。这样,您的公司可以更快地确认污染事件,避免生产线停工,加速产品放行,更快地将产品投放市场,降低库存成本。更早得到微生物实验结果使您能够对您的生产工艺有更好的控制和了解。
如欧盟及世界卫生组织发布的无菌药品GMP附录征求意见稿(简称欧盟无菌附录)10.3章节提到:
“The bioburden assay should be performed on each batch for both aseptically filled product and terminally sterilized products and the results considered as part of the final batch review. There should be defined limits for bioburden immediately before the sterilizing filter or the terminal sterilization process, which are related to the efficiency of the method to be used. Samples should be taken to be representative of the worst case scenario (e.g. at the end of hold time). Where overkill sterilization parameters are set for terminally sterilized products, bioburden should be monitored at suitable scheduled intervals.”
应检测每批无菌灌装药品和终端灭菌药品的生物负载,并将其结果作为最终批审核的一部分纳入考量。应规定除菌过滤或终端灭菌工艺前的生物负载限度,该限度与灭菌功效有关。取样应代表最差情形(例如,在保存时间结束时)。如果终端灭菌产品设定了过度杀灭参数,则应以适当的时间间隔监测生物负载。
同样在中国GMP附录1 无菌药品 第十章第五十八条提到:
应当根据所用灭菌方法的效果确定灭菌前产品微生物污染水平的监控标准,并定期监控。必要时,还应当监控热原或细菌内毒素。
增产增量的后疫情阶段,默克EZ-FluoTM 微生物快速检测系统能够帮助您更快更准确地得到结果,既能匹配膜过滤法又能同时满足法规要求,避免了传统微生物学方法数天的结果等待时间,进而,加速产品放行,更快地将产品投放到市场,降低库存成本。
EZ-FluoTM快速检测系统来满足您的需要
这是一种通过荧光染色法,设计用于可过滤产品的快速微生物计数检测的技术。这一简单易用的系统应用标准的工业薄膜过滤技术来培养单个样品中低至1CFU活的可培养的微生物。该方法是基于传统的薄膜过滤法,因此任何实验室都可以对此快速检测系统进行验证。非破坏性的方法同时也让您能够对一开始在荧光染色过程中发现的任一微生物使用您现有的鉴定方法进行微生物菌种鉴定。

简单快速,只需传统方法的三分之一的时间

基于被证明有效的技术
系统基于两种被广泛证明有效的技术:薄膜过滤法和荧光染色技术。
默克EZ-Fluo™利用广泛接受的Microfil薄膜过滤装置进行样品处理,保证了结果的一致性和可靠性。同时可以使用EFFU/Oasis漏斗进行大体积样品的检测。这一独特的设计保证了所有可能抑制微生物生长的物质能够被冲洗掉。
过滤和培养过后,截留在滤膜上的活的可培养的微生物被试剂中的荧光染色标记所染色。反应原理是在不发光的底物在活性微生物中参与新陈代谢时发生酶解反应。一旦在细胞内分解,底物将独立的发光基团释放到微生物的细胞质中。
当发光基团在细胞内累积后,信号自然被放大。然后细胞被暴露在EZ-Fluo™读数器中会被特定波长的光线所激发,从而得到显示并被计数。

允许后续的鉴定
非破坏性的默克EZ-Fluo™系统不仅能快速得出检测结果,同时使您能够继续对微生物进行培养,以对他们使用任何标准的鉴定技术进行菌种鉴定。
市面上常见的快速检测系统会对微生物造成破坏,一旦发生微生物污染事件,调查和微生物的鉴定会受到限制。这会在您的调查过程中造成严重的影响,使您在对根本原因调查分析和纠偏/ 预防(CAPA)计划时得不到这方面的帮助。
如有您拥有的EZ-Fluo™系统,您的QC分析人员就可以将检出的微生物在再培养后分离出来。微生物可以使用现有的鉴定方法(生化法,形态法,核酸分析法,等)做进一步的菌种鉴定。
基于薄膜过滤法和染色技术原理:染色剂在细胞外时不发荧光,只有活的微生物才能被染色,当微生物代谢后,荧光素在微生物体内累积后,染色微生物暴露在一定波长下,激发荧光,可通过滤光器观察或摄像头显示在屏幕上。

操作示意图

如需了解更多,请参见以下视频
https://v.qq.com/x/page/y3000955fw1.html
此时,更有效地监测产品质量,对生产过程的微生物污染监控对于企业而言非常重要。然而,传统的微生物学方法非常缓慢,需要数天才能得到结果。为了跟上现今产量增长的需求,您需要更快更准确地得到结果。这样,您的公司可以更快地确认污染事件,避免生产线停工,加速产品放行,更快地将产品投放市场,降低库存成本。更早得到微生物实验结果使您能够对您的生产工艺有更好的控制和了解。
如欧盟及世界卫生组织发布的无菌药品GMP附录征求意见稿(简称欧盟无菌附录)10.3章节提到:
“The bioburden assay should be performed on each batch for both aseptically filled product and terminally sterilized products and the results considered as part of the final batch review. There should be defined limits for bioburden immediately before the sterilizing filter or the terminal sterilization process, which are related to the efficiency of the method to be used. Samples should be taken to be representative of the worst case scenario (e.g. at the end of hold time). Where overkill sterilization parameters are set for terminally sterilized products, bioburden should be monitored at suitable scheduled intervals.”
应检测每批无菌灌装药品和终端灭菌药品的生物负载,并将其结果作为最终批审核的一部分纳入考量。应规定除菌过滤或终端灭菌工艺前的生物负载限度,该限度与灭菌功效有关。取样应代表最差情形(例如,在保存时间结束时)。如果终端灭菌产品设定了过度杀灭参数,则应以适当的时间间隔监测生物负载。
同样在中国GMP附录1 无菌药品 第十章第五十八条提到:
应当根据所用灭菌方法的效果确定灭菌前产品微生物污染水平的监控标准,并定期监控。必要时,还应当监控热原或细菌内毒素。
增产增量的后疫情阶段,默克EZ-FluoTM 微生物快速检测系统能够帮助您更快更准确地得到结果,既能匹配膜过滤法又能同时满足法规要求,避免了传统微生物学方法数天的结果等待时间,进而,加速产品放行,更快地将产品投放到市场,降低库存成本。
EZ-FluoTM快速检测系统来满足您的需要
这是一种通过荧光染色法,设计用于可过滤产品的快速微生物计数检测的技术。这一简单易用的系统应用标准的工业薄膜过滤技术来培养单个样品中低至1CFU活的可培养的微生物。该方法是基于传统的薄膜过滤法,因此任何实验室都可以对此快速检测系统进行验证。非破坏性的方法同时也让您能够对一开始在荧光染色过程中发现的任一微生物使用您现有的鉴定方法进行微生物菌种鉴定。

简单快速,只需传统方法的三分之一的时间

基于被证明有效的技术
系统基于两种被广泛证明有效的技术:薄膜过滤法和荧光染色技术。
默克EZ-Fluo™利用广泛接受的Microfil薄膜过滤装置进行样品处理,保证了结果的一致性和可靠性。同时可以使用EFFU/Oasis漏斗进行大体积样品的检测。这一独特的设计保证了所有可能抑制微生物生长的物质能够被冲洗掉。
过滤和培养过后,截留在滤膜上的活的可培养的微生物被试剂中的荧光染色标记所染色。反应原理是在不发光的底物在活性微生物中参与新陈代谢时发生酶解反应。一旦在细胞内分解,底物将独立的发光基团释放到微生物的细胞质中。
当发光基团在细胞内累积后,信号自然被放大。然后细胞被暴露在EZ-Fluo™读数器中会被特定波长的光线所激发,从而得到显示并被计数。
允许后续的鉴定
非破坏性的默克EZ-Fluo™系统不仅能快速得出检测结果,同时使您能够继续对微生物进行培养,以对他们使用任何标准的鉴定技术进行菌种鉴定。
市面上常见的快速检测系统会对微生物造成破坏,一旦发生微生物污染事件,调查和微生物的鉴定会受到限制。这会在您的调查过程中造成严重的影响,使您在对根本原因调查分析和纠偏/ 预防(CAPA)计划时得不到这方面的帮助。
如有您拥有的EZ-Fluo™系统,您的QC分析人员就可以将检出的微生物在再培养后分离出来。微生物可以使用现有的鉴定方法(生化法,形态法,核酸分析法,等)做进一步的菌种鉴定。
基于薄膜过滤法和染色技术原理:染色剂在细胞外时不发荧光,只有活的微生物才能被染色,当微生物代谢后,荧光素在微生物体内累积后,染色微生物暴露在一定波长下,激发荧光,可通过滤光器观察或摄像头显示在屏幕上。

操作示意图

如需了解更多,请参见以下视频
https://v.qq.com/x/page/y3000955fw1.html












